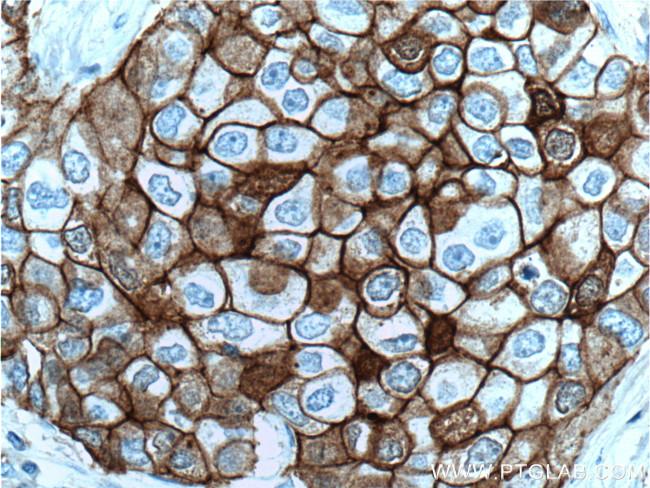
E-cadherin Antibody in Immunohistochemistry (Paraffin) (IHC (P))

Search
Proteintech
E-cadherin Monoclonal Antibody (6B11F11)
{{$productOrderCtrl.translations['antibody.pdp.commerceCard.promotion.promotions']}}
{{$productOrderCtrl.translations['antibody.pdp.commerceCard.promotion.viewpromo']}}
{{$productOrderCtrl.translations['antibody.pdp.commerceCard.promotion.promocode']}}: {{promo.promoCode}} {{promo.promoTitle}} {{promo.promoDescription}}. {{$productOrderCtrl.translations['antibody.pdp.commerceCard.promotion.learnmore']}}
产品信息
60335-1-IG
种属反应
已发表种属
宿主/亚型
分类
类型
克隆号
抗原
偶联物
形式
浓度
规格
纯化类型
保存液
内含物
保存条件
运输条件
产品详细信息
Immunogen sequence: PIFNPTTYK GQVPENEANV VITTLKVTDA DAPNTPAWEA VYTILNDDGG QFVVTTNPVN NDGILKTAKG LDFEAKQQYI LHVAVTNVVP FEVSLTTSTA TVTVDVLDVN EAPIFVPPEK RVEVSEDFGV GQEITSYTAQ EPDTFMEQKI TYRIWRDTAN WLEINPDTGA ISTRAELDRE DFEHVKNSTY TALIIATDNG SPVATGTGTL LLILSDVNDN APIPEPRTIF FCERNPKPQV INIIDADLPP I (373-622 aa encoded by BC141838)
靶标信息
E-Cadherin (epithelial cadherin) is a classical cadherin from the cadherin (alcium dependent adhesion protein) superfamily. The encoded protein is a calcium dependent cell-cell adhesion glycoprotein comprised of five extracellular cadherin repeats, a transmembrane region and a highly conserved cytoplasmic tail. Mutations in this gene are correlated with gastric, breast, colorectal, thyroid and ovarian cancer. Loss of function is thought to contribute to progression in cancer by increasing proliferation, invasion, and/or metastasis. The ectodomain of this protein mediates bacterial adhesion to mammalian cells and the cytoplasmic domain is required for internalization. Identified transcript variants arise from mutation at consensus splice sites. E-cadherin plays a central role in the growth and development of cells by controlling tissue architecture, and maintenance of tissue integrity. In humans, E-cadherin is encoded by the CDH1 gene present on chromosome 16. Studies have demonstrated that reduction and/or loss of E-cadherin expression in carcinomas correlates positively with the potential of these tumors for invasion and metastasis.
仅用于科研。不用于诊断过程。未经明确授权不得转售。
生物信息学
蛋白别名: cadherin 1, E-cadherin (epithelial); cadherin 1, type 1, E-cadherin (epithelial); cadherin e; Cadherin-1; cadherin-E; calcium-dependent adhesion protein, epithelial; CAM 120/80; CD324; cell-CAM 120/80; E-cadherin; E-cadherin 1; Ecadherin; epididymis secretory sperm binding protein; Epithelial cadherin; unnamed protein product; Uvomorulin
基因别名: Arc-1; BCDS1; CD324; CDH1; CDHE; E-cadherin; ECAD; LCAM; UVO
UniProt ID: (Human) P12830, (Rat) Q9R0T4
Entrez Gene ID: (Human) 999, (Pig) 100048953, (Rat) 83502